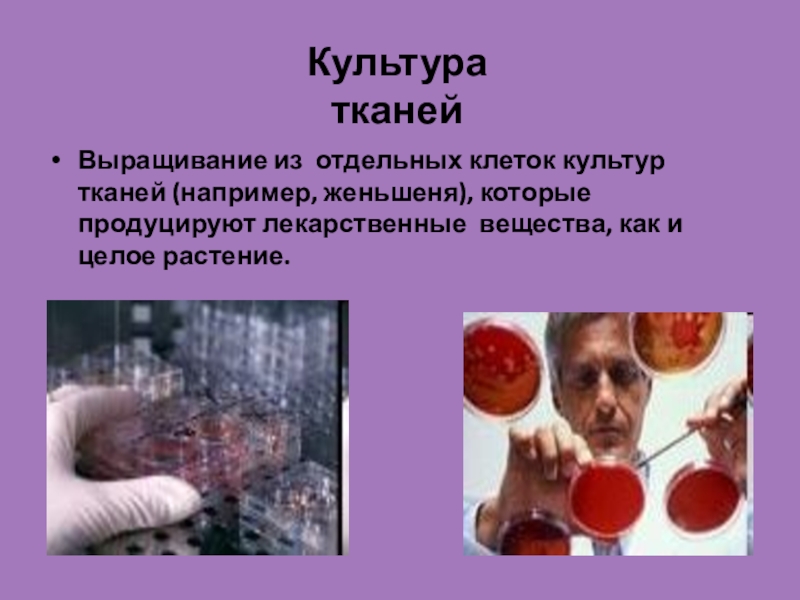

- Главная
- Разное
- Образование
- Спорт
- Естествознание
- Природоведение
- Религиоведение
- Французский язык
- Черчение
- Английский язык
- Астрономия
- Алгебра
- Биология
- География
- Геометрия
- Детские презентации
- Информатика
- История
- Литература
- Математика
- Музыка
- МХК
- Немецкий язык
- ОБЖ
- Обществознание
- Окружающий мир
- Педагогика
- Русский язык
- Технология
- Физика
- Философия
- Химия
- Шаблоны, фоны, картинки для презентаций
- Экология
- Экономика
Презентация, доклад к уроку Генная и клеточная инженерия
Содержание
- 1. Презентация к уроку Генная и клеточная инженерия
- 2. Генная инженерия
- 3. Генная инженерия – это искусственный перенос нужных
- 4. Генная инженерия в медицине.Получение человеческого инсулина в
- 5. Клеточная инженерия
- 6. Клеточная инженерияБольшой вклад в биологию клетки вносят
- 7. Культура тканейВыращивание из отдельных клеток культур тканей
- 8. Гибридизация клеток различных видов растений Сливаются
- 9. Создание гибридомГибридизация животных клеток. Гибридомы, полученные в
- 10. Клонирование
- 11. Что такое клонирование?КЛОНИРОВАНИЕ - воспроизведение генетически однородных
- 12. Слайд 12
- 13. Слайд 13
- 14. Подумаем ! Этично ли проводить генетические эксперименты на человеке?
- 15. Подумаем ! Этичны ли эксперименты над животными?
- 16. «Этичность применения генных
Генная инженерия
Слайд 3Генная инженерия – это искусственный перенос нужных генов от одного вида
живых организмов
(бактерий, животных, растений) в другой вид, часто очень отдаленный по происхождению.
Трансгенные организмы - животные, растения, микроорганизмы, вирусы, геном которых изменен.
(бактерий, животных, растений) в другой вид, часто очень отдаленный по происхождению.
Трансгенные организмы - животные, растения, микроорганизмы, вирусы, геном которых изменен.
Слайд 4Генная инженерия в медицине.
Получение человеческого инсулина в промышленных масштабах;
Разработка интерферона.
Около
200 новых диагностических препаратов (не белковых, а генных) уже введены в медицинскую практику,
Более 100 генно-инженерных лекарственных веществ находится на стадии клинического изучения.
Более 100 генно-инженерных лекарственных веществ находится на стадии клинического изучения.
Слайд 6Клеточная инженерия
Большой вклад в биологию клетки вносят методы клеточной инженерии.
Клеточная инженерия
– область биотехнологии, основанная на культивировании клеток и тканей на питательных средах.
Клеточная инженерия тесно связанна с генной инженерией.
Слайд 7Культура тканей
Выращивание из отдельных клеток культур тканей (например, женьшеня), которые продуцируют
лекарственные вещества, как и целое растение.
Слайд 8Гибридизация клеток различных видов растений
Сливаются клетки растений, относящихся к разным
видам, например, картофеля и томата. Это путь к созданию новых видов растений.
Слайд 9Создание гибридом
Гибридизация животных клеток.
Гибридомы, полученные в результате объединения лимфоцитов и
раковых клеток, вырабатывают антитела, как лимфоциты, и бессмертны, как раковые клетки. Интерферон, который получают с помощью гибридом, применяется для лечения заболеваний.
Слайд 11Что такое клонирование?
КЛОНИРОВАНИЕ - воспроизведение генетически однородных организмов путём бесполого размножения.
При клонировании исходный организм служит родоначальником клона – ряда организмов, повторяющих из поколения в поколение и генотип, и все признаки родоначальника. Таким образом, сущность клонирования заключается в повторении одной и той же генетической информации.
Яйцеклетка
Клетка тела
Ядра клеток удаляются
Ядро клетки тела внедряется в яйцеклетку
Клонированная клетка становится эмбрионом
Стволовые клетки, полученные из эмбрионов.
Слайд 16 «Этичность применения генных и клеточных технологий».
Ваше
мнение?
Домашнее задание § 67, небольшое рассуждение на тему: